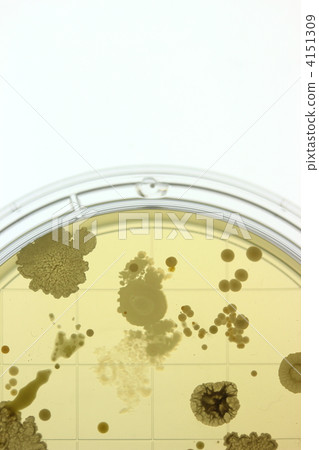

實際貼壁細菌培養[4151309],此圖庫照片素材(圖片)具有培養皿,培養液,細胞的關鍵詞。此照片素材是naoswork / (No.162586)的作品。您可以購買圖小從影像尺寸從S至XLUS$5.00以上的尺寸。註冊成為免費會員後,您可以下載帶有浮水印的圖片以確認畫質及使用收藏夾的服務。 查看全部
版權 : naoswork / PIXTA
閱覽此素材的更多相關資訊
- 關於模特攝影使用授權和所有物權使用合同
- 創建日 : 2012-02-09
- 查看數 : 777
- 過去的購買履歷 : 無
- 關於此素材的具體信息,請諮詢賣家。